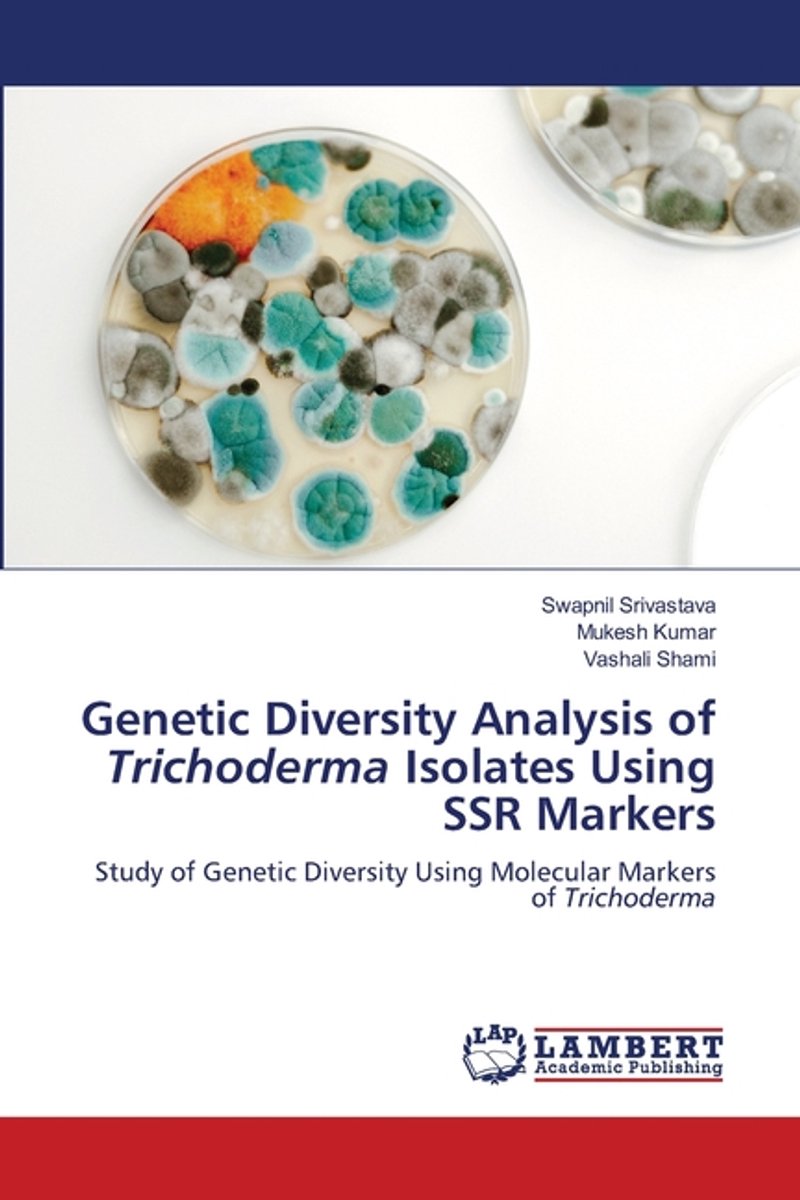

We hebben 2 boeken gevonden van de auteur Swapnil Srivastava
Hieronder vindt u een lijst met alle gevonden boeken van de auteur Swapnil Srivastava.
De meest gevonden boeken zijn Genetic Diversity Analysis Of Trichoderma Isolates Using Ssr Markers en Genetic Diversity Analysis Of Trichoderma Isolates.
De meest gevonden boeken zijn Genetic Diversity Analysis Of Trichoderma Isolates Using Ssr Markers en Genetic Diversity Analysis Of Trichoderma Isolates.
Sorteer op: